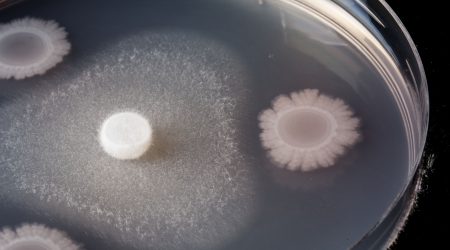

Upcoming Biochemical Society Seminars
We are currently planning seminars through to Autumn 2021
Read about upcoming biochemical society seminarsFeaturing speakers with interests in chemical biology, food-related biochemistry, and plant and microbial biochemistry
The seminars will take place at various institutes across the Norwich Research Park (NRP).
Biochemistry underpins much of the scientific endeavour that takes place on the NRP, and this series aims to bring together scientists from the University of East Anglia (UEA), the Norfolk and Norwich University Hospital, and four independent world-renowned research institutes: the John Innes Centre, Quadram, Earlham Institute and The Sainsbury Laboratory.
The programme will reflect the diverse interests of the communities from across the NRP, including speakers with interests in chemical biology, food-related biochemistry, and plant and microbial biochemistry. To deliver a broad audience and impact for the seminar series, the seminars will take place in different places across the NRP, be free to attend and scheduled to ensure the widest possible attendance, including undergraduate and postgraduate students, and other partners from across the NRP.

We are currently planning seminars through to Autumn 2021
Read about upcoming biochemical society seminars
Previous Biochemical Society Seminar speakers and titles
Read about past biochemical society seminars